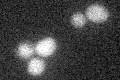
YDL219W
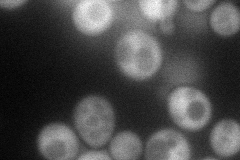
YDL219W
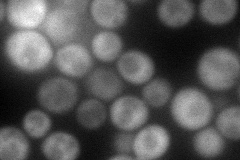
YDL219W
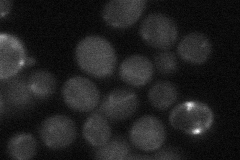
YDL219W
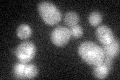
YDL219W
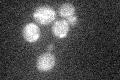
YDL219W

View description
D-Tyr-tRNA(Tyr) deacylase, functions in protein translation, may affect nonsense suppression via alteration of the protein synthesis machinery; ubiquitous among eukaryotes
Localization:
Intensity:
Fold change:
Significance:
-
C’ GFP library in SD
below threshold19.11 -
N' NOP1pr-GFP in SD
cytosol67.7836 -
N' TEF2pr-mCherry in SD
cytosol81.617 -
N' NATIVEpr-GFP in SD
below threshold25.331 -
N' TEF2pr-VC and Cyto-VN in SD

#N/A0 -
C’ GFP library in SD+DTT
cytosol14.980.78No -
C’ GFP library in SD+H2O2
cytosol13.840.72No -
C’ GFP library in Starvation Media

cytosol16.270.85No -
C’ GFP library on the background of Pup2-DaMP

below threshold -
C’ GFP library on the background of CCT mutant

below threshold16.8620.882139No
